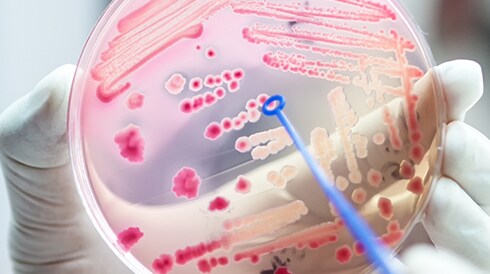
Improving Antimicrobial Resistance Detection

Sepsis Resource Center

According to the U.S. Centers for Disease Control and Prevention, at least 1.7 million adults in the U.S. develop sepsis each year.1 The Association of American Medical Colleges reports that 80% of deaths due to sepsis could be prevented if treated in time.2 The Fisher Healthcare channel is committed to supporting your needs as you fight this devastating condition.
Explore our curated collection of specialized products and resources designed to streamline your workflows and aid in the research, diagnosis, and treatment of sepsis.
Collection
Catalog Number 22024239
Catalog Number 22024240
Catalog Number 02683172
Catalog Number 02687100
Catalog Number 23232002
Diagnosis
Catalog Number B441385
Catalog Number B442296
Catalog Number R01300
Catalog Number R01550
Catalog Number R01580
Catalog Number R01200
Catalog Number R01660
Catalog Number 23180002
Treatment
Catalog Number B1890133
Catalog Number B443624
Catalog Number YV3000VZ
Resources
Sources
1. U.S. Centers for Disease Control and Prevention. About Sepsis. https://www.cdc.gov/sepsis/about/index.html
2. Balch, B. (2023, October 10). Sepsis is the third leading cause of death in U.S. hospitals. But quick action can save lives. Association of American Medical Colleges. https://www.aamc.org/news/sepsis-third-leading-cause-death-us-hospitals-quick-action-can-save-lives